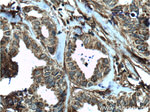
MCT4 Antibody in Immunohistochemistry (Paraffin) (IHC (P))
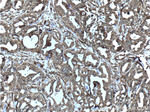
MCT4 Antibody in Immunohistochemistry (Paraffin) (IHC (P))
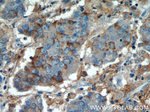
MCT4 Antibody in Immunohistochemistry (Paraffin) (IHC (P))

Search
Proteintech
MCT4 Polyclonal Antibody
{{$productOrderCtrl.translations['antibody.pdp.commerceCard.promotion.promotions']}}
{{$productOrderCtrl.translations['antibody.pdp.commerceCard.promotion.viewpromo']}}
{{$productOrderCtrl.translations['antibody.pdp.commerceCard.promotion.promocode']}}: {{promo.promoCode}} {{promo.promoTitle}} {{promo.promoDescription}}. {{$productOrderCtrl.translations['antibody.pdp.commerceCard.promotion.learnmore']}}
产品信息
22787-1-AP
种属反应
已发表种属
宿主/亚型
分类
类型
抗原
偶联物
形式
浓度
规格
纯化类型
保存液
内含物
保存条件
运输条件
产品详细信息
Immunogen sequence: LLLGNFFCI RKKPKEPQPE VAAAEEEKLH KPPADSGVDL REVEHFLKAE PEKNGEVVHT PETSV (402-465 aa encoded by BC112269)
靶标信息
Lactic acid and pyruvate transport across plasma membranes is catalyzed by members of the proton-linked monocarboxylate transporter (MCT) family, which has been designated solute carrier family-16. Each MCT appears to have slightly different substrate and inhibitor specificities and transport kinetics, which are related to the metabolic requirements of the tissues in which it is found. The MCTs, which include MCT1 (SLC16A1; MIM 600682) and MCT2 (SLC16A7; MIM 603654), are characterized by 12 predicted transmembrane domains (Price et al., 1998 [PubMed 9425115]).
仅用于科研。不用于诊断过程。未经明确授权不得转售。
生物信息学
蛋白别名: MCT 3; MCT 4; MGC138472; MGC138474; monocarboxylate transporter; Monocarboxylate transporter 3; Monocarboxylate transporter 4; MOT4; solute carrier family 16 (monocarboxylate transporter), member 3; solute carrier family 16 (monocarboxylic acid transporters), member 3; Solute carrier family 16 member 3; solute carrier family 16, member 3 (monocarboxylic acid transporter 4); unnamed protein product
基因别名: MCT 3; MCT 4; MCT-3; MCT-4; MCT3; MCT4; SLC16A3
UniProt ID: (Human) O15427, (Rat) O35910
Entrez Gene ID: (Human) 9123, (Rat) 80878